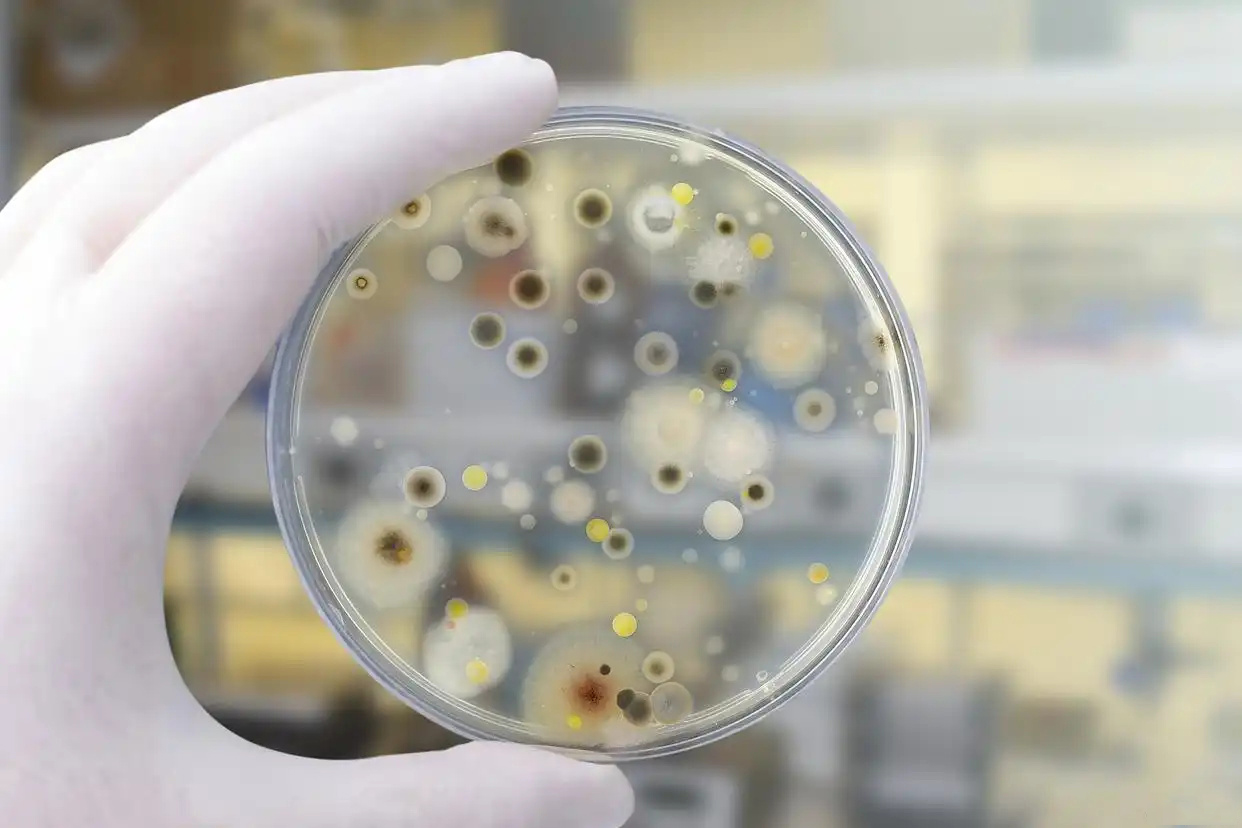
3.jpg

原代细胞是指从组织中刚刚分离出来的没有经过传代的细胞。原代细胞通常具有较高的生物活性和表型稳定性,因此在科学研究和医学应用中有着广泛的应用。然而,由于原代细胞的生物学特性以及操作技术的要求较高,对于绝大多数科研人员和医学工作者而言,原代细胞的分离和培养并不是一项容易的工作。下面,我们将详细介绍原代细胞分离和培养的具体操作步骤和注意事项。

1. 原代细胞的分离
(1)组织样品的准备
组织样品的选择和处理是原代细胞分离的第一步。对于大多数组织而言,原代细胞的分离需要利用消化酶来破坏组织的细胞间质和胶原纤维,释放出单个细胞。因此,组织样品的处理需要将组织细胞的粘附和成团化去除,以方便酶的进入,并且避免酶的作用受到组织间隙的阻碍。这一步骤通常包括将组织样品切碎、磨碎、离心、过筛等处理手段。
(2)酶的选择
酶是原代细胞分离过程中至关重要的因素。不同的酶具有不同的消化程度和特异性,因此酶的选择需要根据组织的类型、来源和所需细胞类型进行。对于典型的原代细胞分离,常用的酶类有胰酶、胶原酶、透明质酸酶等。

(3)消化条件的控制
消化条件的控制包括温度、时间、pH值和酶的浓度等方面。这些因素都需要在试验前进行优化和标准化,以确保消化效果和细胞生存率最佳。一般而言,消化时间和酶的浓度是与细胞获取率和细胞匀浆程度相关的最关键的因素。
(4)细胞的分离
全细胞分离通常是指使用流式细胞仪或磁珠技术来纯化目标细胞类型。然而,在某些情况下,原代细胞的分离可能并不需要完全纯化。如果目标是获得一定数量和比例的细胞,通过离心、上清液分离等方式,也可以达到目的。
2. 原代细胞的培养
(1)培养基的选择
培养基是原代细胞培养的基础,与培养缸的相容性、成本、营养成分等因素有关。常见的培养基有DMEM、RPMI1640、MEM等,不同的细胞需要选择不同的培养基。
(2)培养条件的优化
在外界的体外环境中,细胞的生长需要良好的各种生长因子、营养物质和适当的温度和湿度等条件。在培养过程中,当细胞生长速度过快或过慢时,可以通过调整培养基中营养物质的配比、气体辐射和pH值等因素来加以调节。

(3)细胞分代
细胞的分代是指将原代细胞放置到新的培养缸中,以使细胞得以继续生长和分裂。不同的细胞类型具有不同的分代周期,需要根据实验的需要和细胞生长状况进行选择。
(4)细胞的检测
在细胞培养过程中,需要对细胞的表型、增殖和代谢状态进行长期的监测和检测,以确保实验的有效性和结果的可靠性。常见的检测手段包括显微镜镜检、细胞计数、MTT法、流式细胞仪等。
原代细胞分离和培养是一项繁琐而极具技术性的操作。本文详细介绍了原代细胞分离和培养的操作步骤和注意事项,相信可以帮助读者更好地完成相关的实验和应用。
实验外包 想了解更多请关注:http://www.do-gene.cn

